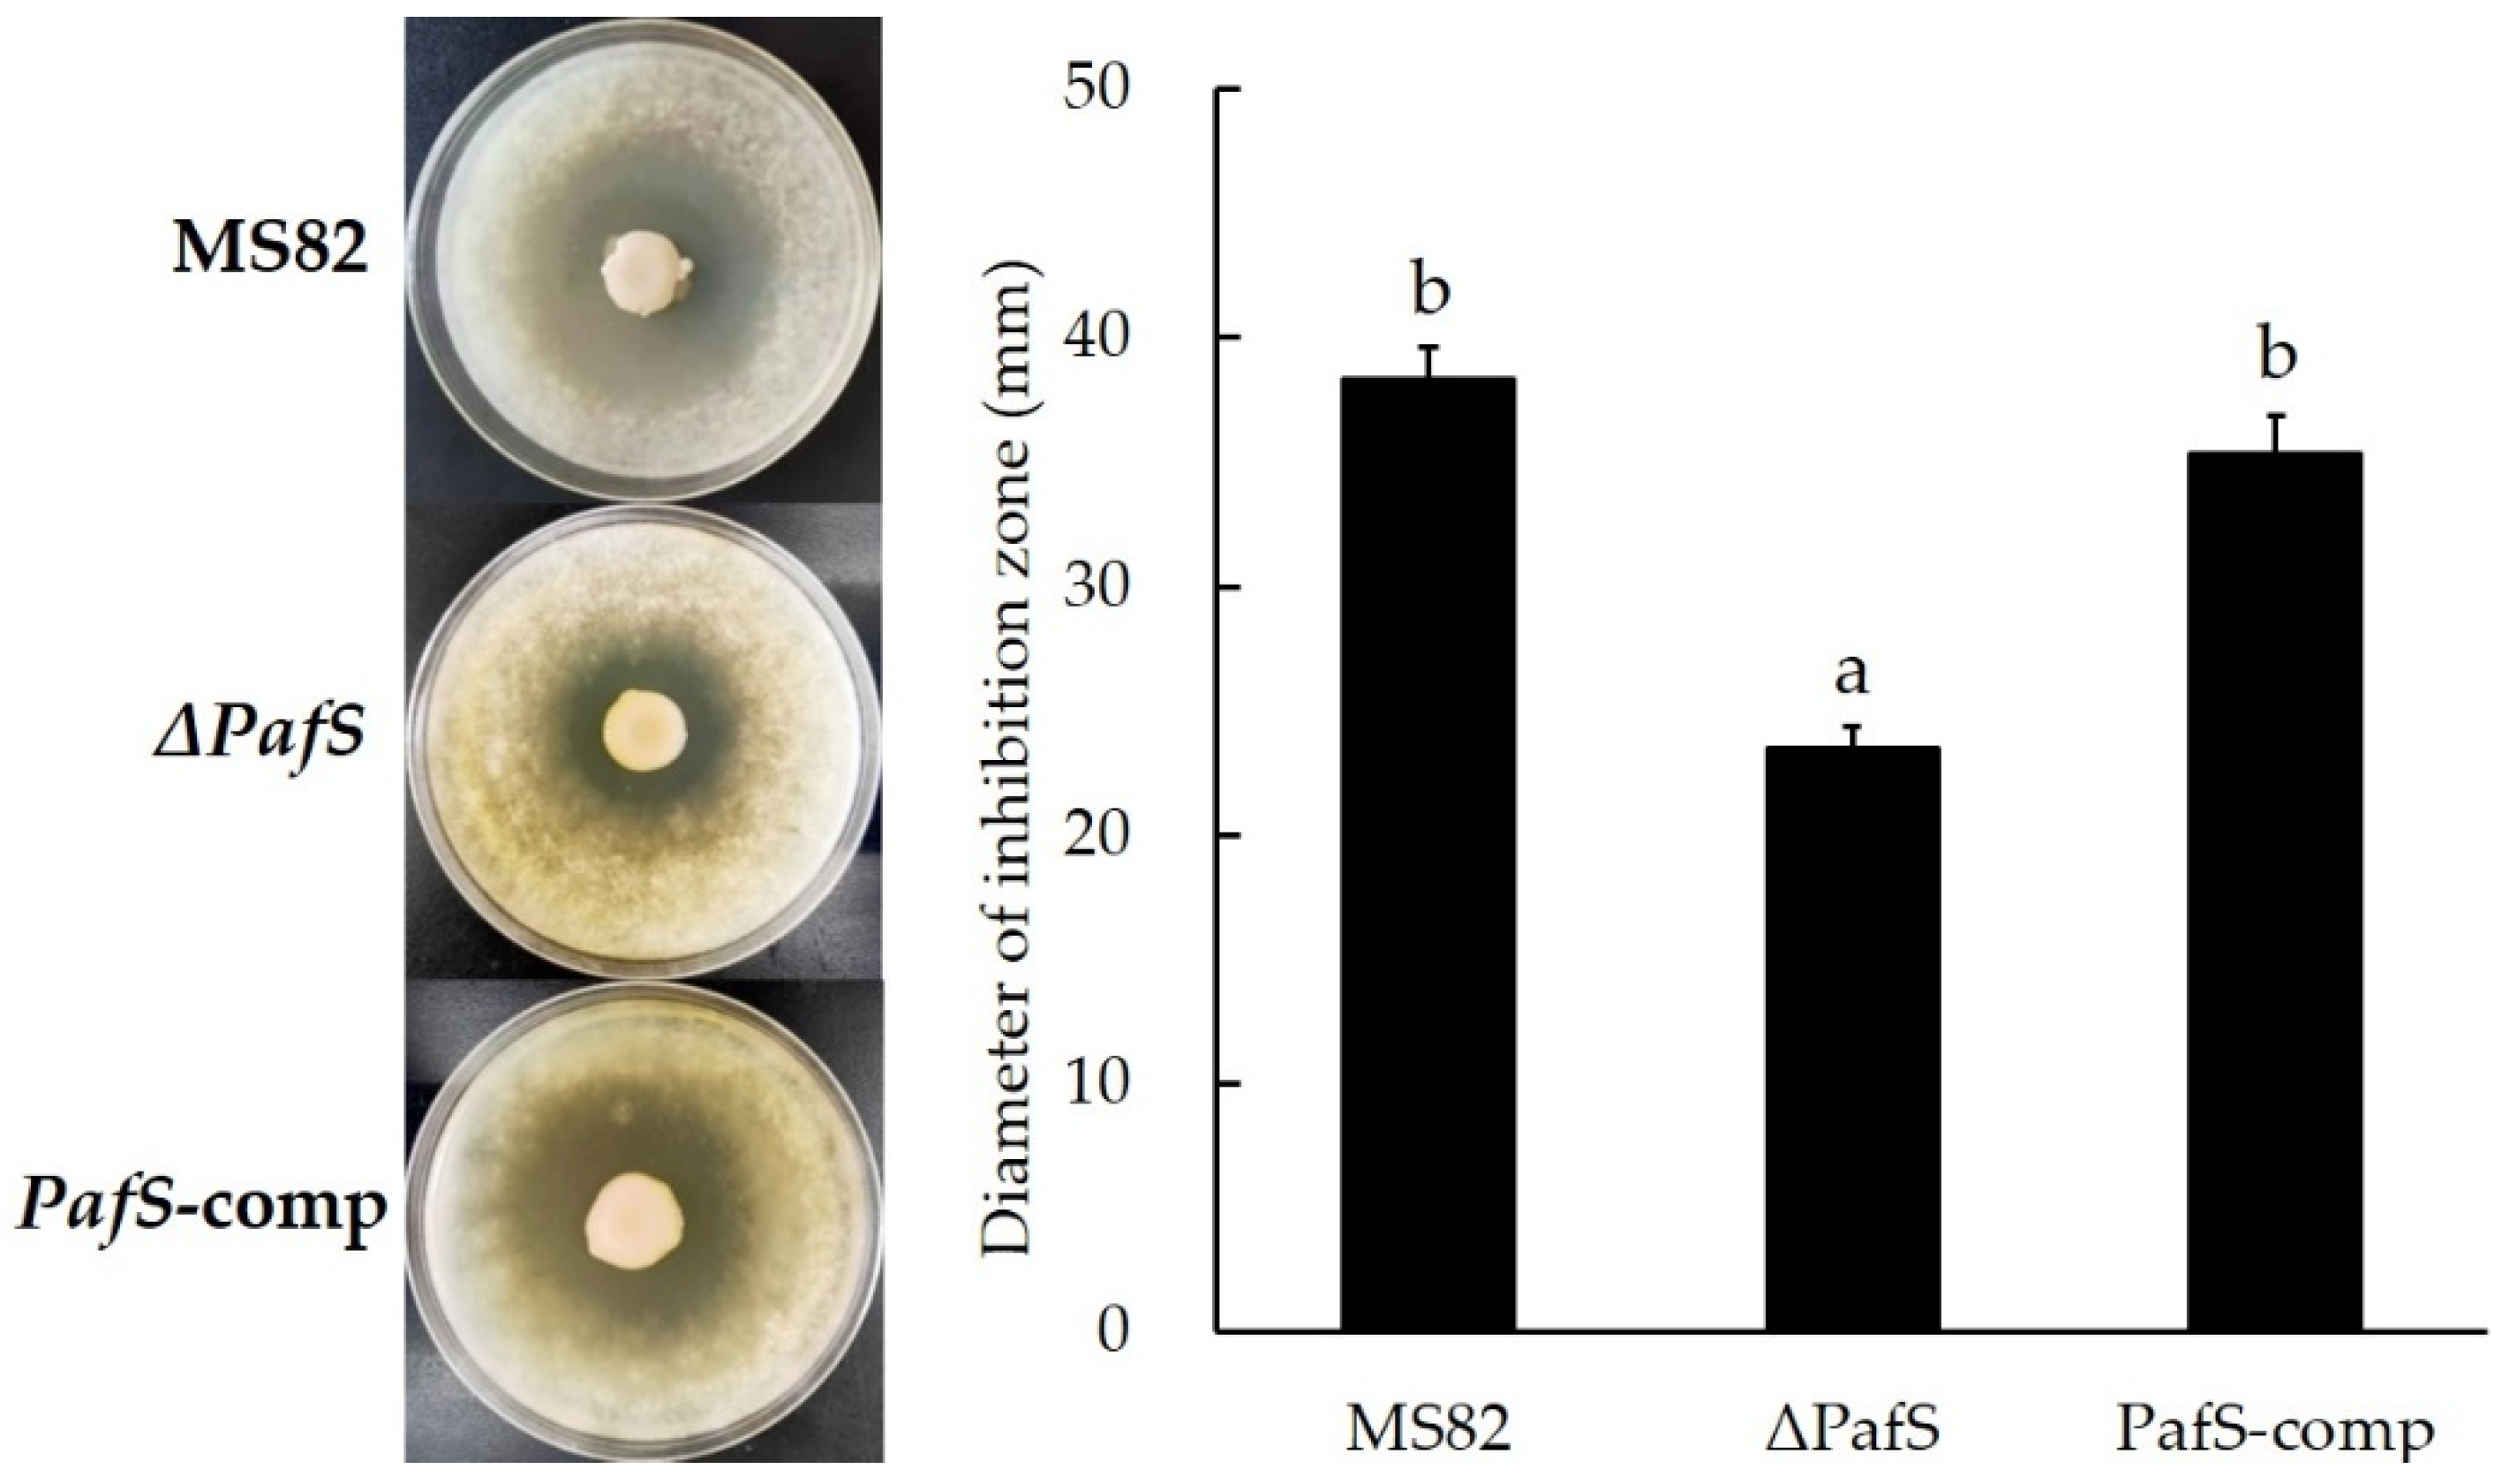
Microorganisms 10 02342 g002 Microorganisms 10 02342 g002

PafS Containing GGDEF-Domain Regulates Life Activities of Pseudomonas glycinae MS82
Abstract
1. Introduction
2. Materials and Methods
2.1. Strains, Plasmids, and Culture Conditions
2.2. Deletion and Complementation of PafS
2.3. Antifungal Activity Bioassay
2.4. Biofilm Formation Assay
2.5. Extracellular Polysaccharides (EPS) Synthesis Assay
2.6. Motility Assay
3. Results
3.1. Deletion and Complementation of PafS
3.2. Antifungal Activity Bioassay
3.3. Biofilm Formation Assay
3.4. Extracellular Polysaccharides Synthesis Assay
3.5. Motility Assay
4. Discussion
Author Contributions
Funding
Data Availability Statement
Conflicts of Interest
References
- Ross, P.; Weinhouse, H.; Aloni, Y.; Michaeli, D.; Weinberger, O.P.; Mayer, R.; Braun, S.; Vroom, E.; Marel, G.A.; Boom, J.H.; et al. Regulation of cellulose synthesis in Acetobacter xylinum by cyclic diguanylic acid. Nature 1987, 325, 279–281. [Google Scholar] [CrossRef]
- Paul, R.; Stefan, W.; Nicholas, C.A.; Carmen, C.; Tilman, S.; Bernd, G.; Urs, J. Cell cycle-dependent dynamic localization of a bacterial response regulator with a novel diguanylate cyclase output domain. Genes Dev. 2004, 18, 715–727. [Google Scholar] [CrossRef]
- Pei, J.; Grishin, N.V. GGDEF domain is homologous to adenylyl cyclase. Proteins Struct. Funct. Bioinform. 2000, 42, 210–216. [Google Scholar] [CrossRef]
- Hengge, R. Principles of c-di-GMP signaling in bacteria. Nat. Rev. Microbiol. 2009, 7, 263–273. [Google Scholar] [CrossRef] [PubMed]
- Römling, U.; Galperin, M.Y.; Gomelsky, M. Cyclic di-GMP: The first 25 years of a universal bacterial second messenger. Microbiol. Mol. Biol. R. 2013, 77, 1–52. [Google Scholar] [CrossRef]
- Ryjenkov, D.A.; Simm, R.; Rmling, U.; Gomelsky, M. The PilZ domain is a receptor for the second messenger c-di-GMP: The PilZ domain protein YcgR controls motility in enterobacteria. J. Biol. Chem. 2006, 281, 30310–30314. [Google Scholar] [CrossRef]
- Hickman, J.W.; Tifrea, D.F.; Harwood, C.S. A chemosensory system that regulates biofilm formation through modulation of cyclic diguanylate levels. PNAS 2005, 102, 14422–14427. [Google Scholar] [CrossRef]
- Chen, M.W.; Kotaka, M.; Vonrhein, C.; Bricogne, G.; Rao, F.; Chuah, M.L.C.; Svergun, D.; Schneider, G.; Liang, Z.X.; Lescar, J. Structural insights into the regulatory mechanism of the response reguator RocR from Pseudomonas aeruginosa in cyclic di-GMP signaling. J. Bacteriol. 2012, 194, 4837–4846. [Google Scholar] [CrossRef] [PubMed]
- Christen, B.; Christen, M.; Paul, R.; Schmid, F.; Folcher, M.; Jenoe, P.; Meuwly, M.; Jenal, U. Allosteric control of cyclic di-GMP signaling. J. Biol. Chem. 2006, 281, 32015–32024. [Google Scholar] [CrossRef]
- Simm, R.; Morr, M.; Kader, A.; Nimtz, M.; Römling, U. GGDEF and EAL domains inversely regulate cyclic di-GMP levels and transition from sessility to motility. Mol. Microbiol. 2004, 53, 1123–1134. [Google Scholar] [CrossRef]
- Rashid, M.H.; Rajanna, C.; Ali, A.; Karaolis, D.K.R. Identification of genes involved in the switch between the smooth and rugose phenotypes of Vibrio cholera. FEMS Microbiol. Lett. 2006, 227, 113–119. [Google Scholar] [CrossRef] [PubMed]
- Rossignol, G.; Sperandio, D.; Guerillon, J.; Duclairoir Poc, C.; Soum-Soutera, E.; Orange, N.; Feuilloley, M.G.J.; Merieau, A. Phenotypic variation in the Pseudomonas fluorescens clinical strain MFN1032. Res. Microbiol. 2009, 160, 337–344. [Google Scholar] [CrossRef] [PubMed]
- Fagerlund, A.; Smith, V.; Røhr, A.K.; Lindbäck, T.; Parmer, M.; Andersson, K.; Reubsaet, L.; Økstad, O. Cyclic diguanylate regulation of Bacillus cereus group biofilm formation. Mol. Microbiol. 2016, 101, 471–494. [Google Scholar] [CrossRef] [PubMed]
- He, Q.; Wang, F.; Liu, S.; Zhu, D.; Cong, H.; Gao, F.; Li, B.; Wang, H.; Lin, Z.; Liao, J.; et al. Structural and biochemical insight into the mechanism of Rv2837c from Mycobacterium tuberculosis as a c-di-NMP phosphodiesterase. J. Biol. Chem. 2016, 291, 2681–3668. [Google Scholar] [CrossRef] [PubMed]
- Ma, L.; Wang, X.; Deng, P.; Baird, S.M.; Liu, Y.; Qu, S.X.; Lu, S.E. The PafR gene is required for antifungal activity of strain MS82 against Mycogone perniciosa. Adv. Microbiol. 2017, 7, 217–230. [Google Scholar] [CrossRef][Green Version]
- Ma, L.; Qu, S.X.; Lin, J.S.; Jia, J.Y.; Baird, M.S.; Jiang, N.; Li, H.P.; Hou, L.J.; Lu, S.E. The complete genome of the antifungal bacterium Pseudomonas sp. strain MS82. J. Plant Dis. Protect. 2019, 126, 153–160. [Google Scholar] [CrossRef]
- Jia, J.; Wang, X.; Deng, P.; Ma, L.; Baird, M.S.; Li, X.; Lu, S.E. Pseudomonas glycinae sp. nov. isolated from the soybean rhizosphere. MicrobiologyOpen 2020, 9, e1101. [Google Scholar] [CrossRef]
- Newell, P.D.; Shiro, Y.; Hvorecny, K.L.; Monds, R.D.; O’Toole, G.A. Systematic analysis of diguanylate cyclases that promote biofilm formation by Pseudomonas fluorescens Pf0-1. J. Bacteriol. 2011, 193, 4685–4698. [Google Scholar] [CrossRef]
- Wang, X.Q.; Liu, A.X.; Guerrero, A.; Liu, J.; Yu, X.Q.; Deng, P.; Ma, L.; Baird, S.M.; Smith, L.; Li, X.D.; et al. Occidiofungin is an important component responsible for the antifungal activity of Burkholderia pyrrocinia strain Lyc2. J. Appl. Microbiol. 2015, 120, 607–618. [Google Scholar] [CrossRef]
- Huertas-Rosales, Ó.; Romero, M.; Heeb, S.; Espinosa-Urgel, M.; Camara, M.; Ramos-Gonzalez, M.I. The Pseudomonas putida CsrA/RsmA homologues negatively affect c-di-GMP pools and biofilm formation through the GGDEF/EAL response regulator CfcR. Environ. Microbiol. 2017, 19, 3551–3566. [Google Scholar] [CrossRef]
- Yang, F.; Qian, S.; Tian, F.; Chen, H.; Hutchins, W.; Yang, C.H.; He, C. The GGDEF-domain protein GdpX1 attenuates motility, exopolysaccharide production and virulence in Xanthomonas oryzae pv.oryzae. J. Appl. Microbiol. 2016, 120, 1646–1657. [Google Scholar] [CrossRef] [PubMed]
- Smet, J.D.; Wagemans, J.; Hendrix, H.; Staes, I.; Visnapuu, A.; Horemans, B.; Aertsen, A.; Lavigne, R. Bacteriophage mediated interference of the c-di-GMP signaling pathway in Pseudomonas aeruginosa. Microb. Biotechnol. 2020, 14, 967–978. [Google Scholar] [CrossRef] [PubMed]
- Keel, C.; Schnider, U.; Maurhofer, M.; Voisard, C.; Laville, J.; Burger, U.; Wirthner, P.; Haas, D.; Défago, G. Suppression of root diseases by Pseudomonas fluorescens CHA0: Importance of the bacterial secondary metabolite 2,4-diacetylphloroglucinol. Mol. Plant-Microbe Interact. 1992, 5, 4–13. [Google Scholar] [CrossRef]
- Don, C.; Yvan, M.L.; Anne, F.; Colum, D.; Dowling, D.N.; Fergal, O.G. Ecological interaction of a biocontrol Pseudomonas fluorescens strain producing 2,4-diacetylphloroglucinol with the soft rot potato pathogen Erwinia carotovora subsp. atroseptica. FEMS Microbiol. Ecol. 1997, 23, 95–106. [Google Scholar] [CrossRef]
- Okegbe, C.; Fields, B.L.; Cole, S.J.; Beierschmitt, C.; Morgan, C.J.; Price-Whelan, A.; Stewart, R.C.; Lee, V.T.; Diethrich, L.E.P. Electron-shuttling antibiotics structure bacterial communities by modulating cellular levels of c-di-GMP. Proc. Natl. Acad. Sci. USA 2017, 114, 5236–5245. [Google Scholar] [CrossRef]
- Hickman, J.W.; Harwood, C.S. Identification of FleQ from Pseudomonas aeruginosa as a c-di-GMP-responsive transcription factor. Mol. Microbiol. 2008, 69, 376–389. [Google Scholar] [CrossRef]
- Liang, Z.X. The expanding roles of c-di-GMP in the biosynthesiss of exopolysaccharides and secondary metabolites. Nat. Prod. Rep. 2015, 32, 663–683. [Google Scholar] [CrossRef]
- Seshasayee, A.S.; Fraser, G.M.; Luscombe, N.M. Comparative genomics of cyclic-di-GMP signaling in bacteria: Post-translational regulation and catalytic activity. Nucleic Acids Res. 2010, 38, 5970–5981. [Google Scholar] [CrossRef]
- Güvener, Z.T.; Harwood, C.S. Subcellular location characteristics of the Pseudomonas aeruginosa GGDEF protein, WspR, indicate that it produces cyclic-di-GMP in response to growth on surfaces. Mol. Microbiol. 2007, 66, 1459–1473. [Google Scholar] [CrossRef]
- Navazo, A.; Barahona, E.; Redondo-Nieto, M.; Martinez-Granero, F.; Rivilla, R.; Martin, M. Three independent signaling pathways repress motility in P. fluorescens F113. Microb. Biotechnol. 2009, 2, 489–498. [Google Scholar] [CrossRef]
- D’Argenio, D.A.; Calfee, M.W.; Rainey, P.B.; Pesci, E.C. Autolysis and autoaggregation in Pseudomonas aeruginosa colony morphology mutants. J. Bacteriol. 2002, 184, 6481–6489. [Google Scholar] [CrossRef] [PubMed]
- Muriel, C.; Arrebola, E.; Redondo-Nieto, M.; Martínez-Granero, F.; Jalvo, B.; Pfeilmeier, S.; Blanco-Romero, E.; Baena, I.; Malone, J.G.; Rivilla, R.; et al. AmrZ is a major determinant of c-di-GMP levels in Pseudomonas fluorescens F113. Sci. Rep. 2018, 8, 1979. [Google Scholar] [CrossRef] [PubMed]
- Lo, Y.L.; Shen, L.; Chang, C.H.; Bhuwan, M.; Chiu, C.H.; Chang, H.Y. Regulation of motility and phenazine pigment production by FliA is cyclic-di-GMP dependent in Pseudomonas aeruginosa PAO1. PLoS ONE 2016, 11, e0155397. [Google Scholar] [CrossRef] [PubMed]

| Strain or Plasmid | Relevant Characteristics | Source |
|---|---|---|
| Pseudomonas glycinae [17] | ||
| MS82 | Wild-type strain, 28 °C, Apr 1 | This study |
| ΔPafS | MS82 with deletion of PafS, 28 °C, Apr | This study |
| PafS -comp | MS82 with reverse of PafS, 28 °C, Apr | This study |
| Escherichia coli | ||
| DH5α | supE44 ΔlacU169 (Φ80 lacZΔM15) hsdR17 recA1 endA1 gyrA96 thi-1 relA1, 37 °C | TSINGKE, Beijing, China |
| S17-1λ | RP4-2(Km::Tn7,Tc::Mu-1), pro-82, LAMpir, recA1, endA1, thiE1, hsdR17, creC510, 37 °C | WEIDI, Shanghai, China |
| Trichoderma virens | ||
| NJ1 | A pathogen isolated from mushroom culture medium | This laboratory |
| Plasmids | ||
| pEX18GM | Suicide vector, SacB, Gmr 2 | FENGHUI, Changsha, China |
| pEX18-ΔPafS | PEX18 with upstream and downstream fragments of PafS, Gmr | This study |
| pEX18-PafS-comp | PEX18 with PafS gene containing upstream and downstream fragments, Gmr | This study |
| Primer | Sequence 5′→3′ | Enzyme | Annealing Temperature |
|---|---|---|---|
| ΔPafS-F1 ΔPafS-R1 | CCAAGCTTGGTAAAGCGTGCGGTGTCCT 1 GGGGTACCCGATCAACCCGGACGAGACT | HindIII KpnI | 55 °C |
| ΔPafS-F2 ΔPafS-R2 | GGGGTACCATGCTGCTTCTCTTGTCGGG GCTCTAGAAAGCGTAGAGGGATTTTTTG | KpnI XbaI | 55 °C |
| PafS-compF PafS-compR | ACGGCCAGTGCCAAGCTTGGTAAAGCGTGCGGTGTC GGTACCCGGGGATCCTCTAGACGTTGATGACTACCCTGAAAATCT | HindIII XbaI | 65 °C |
Publisher’s Note: MDPI stays neutral with regard to jurisdictional claims in published maps and institutional affiliations. |
© 2022 by the authors. Licensee MDPI, Basel, Switzerland. This article is an open access article distributed under the terms and conditions of the Creative Commons Attribution (CC BY) license (https://creativecommons.org/licenses/by/4.0/).
Share and Cite
Chen, X.; Qu, S.; Luo, X.; Lu, S.-E.; Liu, Y.; Li, H.; Hou, L.; Lin, J.; Jiang, N.; Ma, L. PafS Containing GGDEF-Domain Regulates Life Activities of Pseudomonas glycinae MS82. Microorganisms 2022, 10, 2342. https://doi.org/10.3390/microorganisms10122342
Chen X, Qu S, Luo X, Lu S-E, Liu Y, Li H, Hou L, Lin J, Jiang N, Ma L. PafS Containing GGDEF-Domain Regulates Life Activities of Pseudomonas glycinae MS82. Microorganisms. 2022; 10(12):2342. https://doi.org/10.3390/microorganisms10122342
Chicago/Turabian StyleChen, Xianyi, Shaoxuan Qu, Xin Luo, Shi-En Lu, Youzhou Liu, Huiping Li, Lijuan Hou, Jinsheng Lin, Ning Jiang, and Lin Ma. 2022. "PafS Containing GGDEF-Domain Regulates Life Activities of Pseudomonas glycinae MS82" Microorganisms 10, no. 12: 2342. https://doi.org/10.3390/microorganisms10122342
APA StyleChen, X., Qu, S., Luo, X., Lu, S.-E., Liu, Y., Li, H., Hou, L., Lin, J., Jiang, N., & Ma, L. (2022). PafS Containing GGDEF-Domain Regulates Life Activities of Pseudomonas glycinae MS82. Microorganisms, 10(12), 2342. https://doi.org/10.3390/microorganisms10122342

